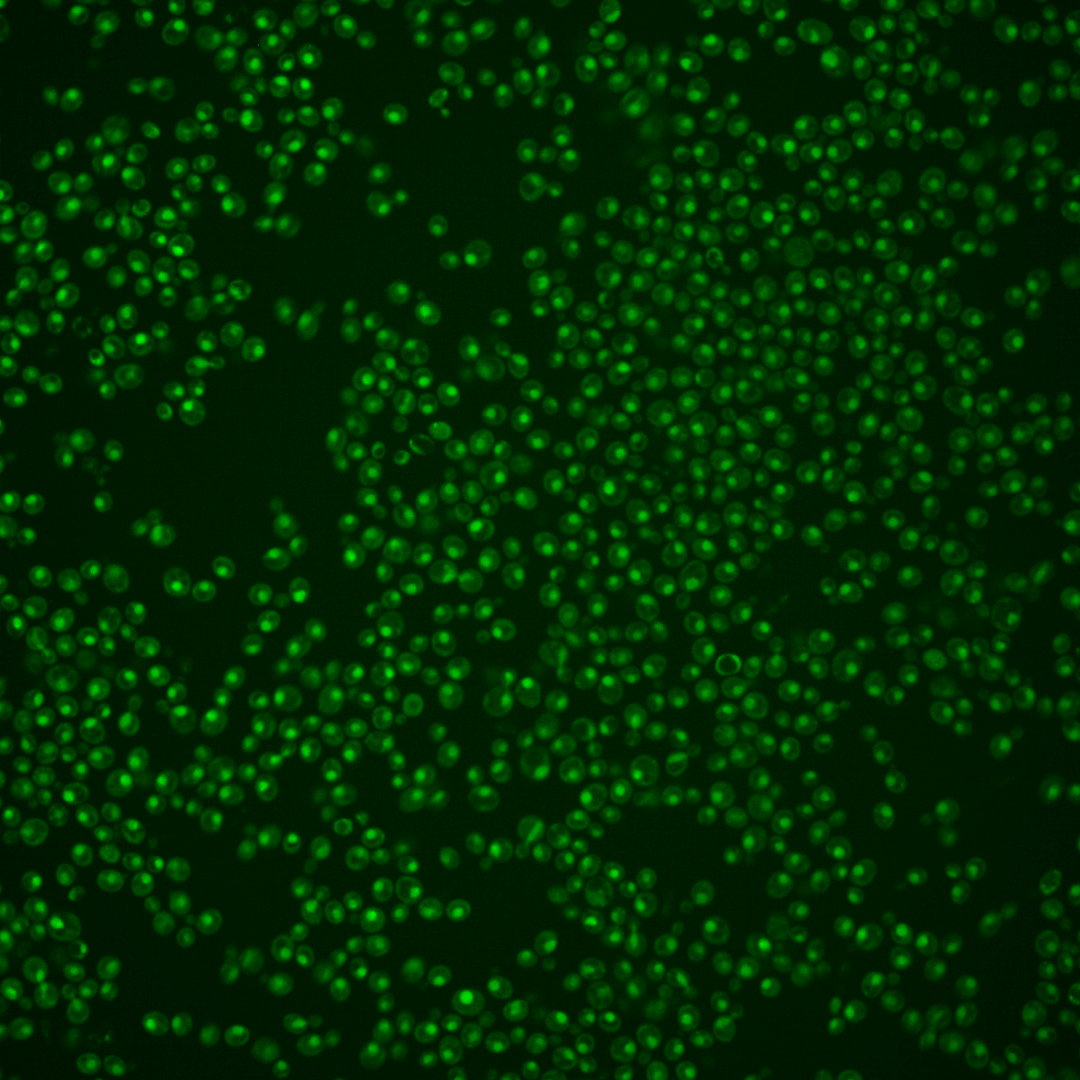
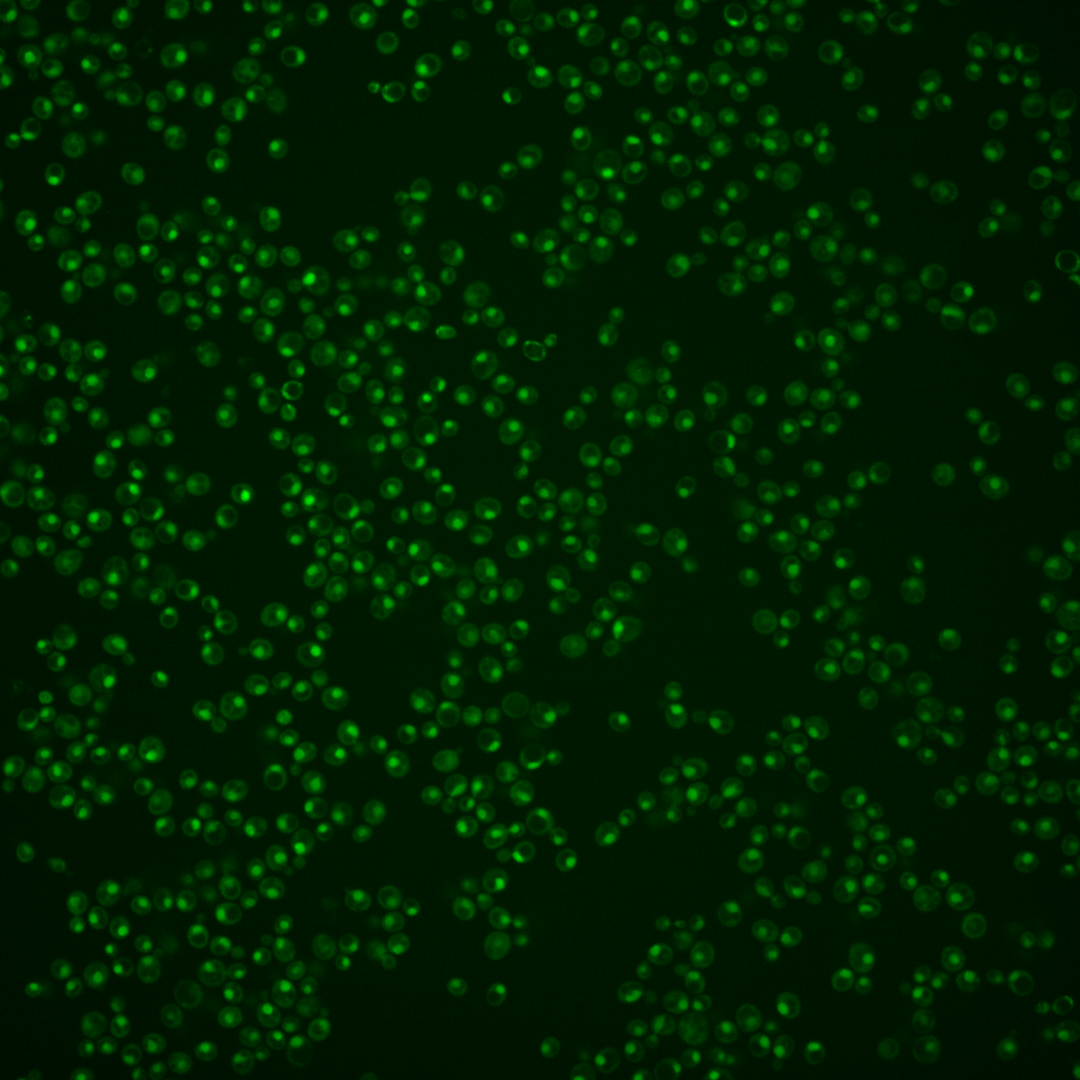
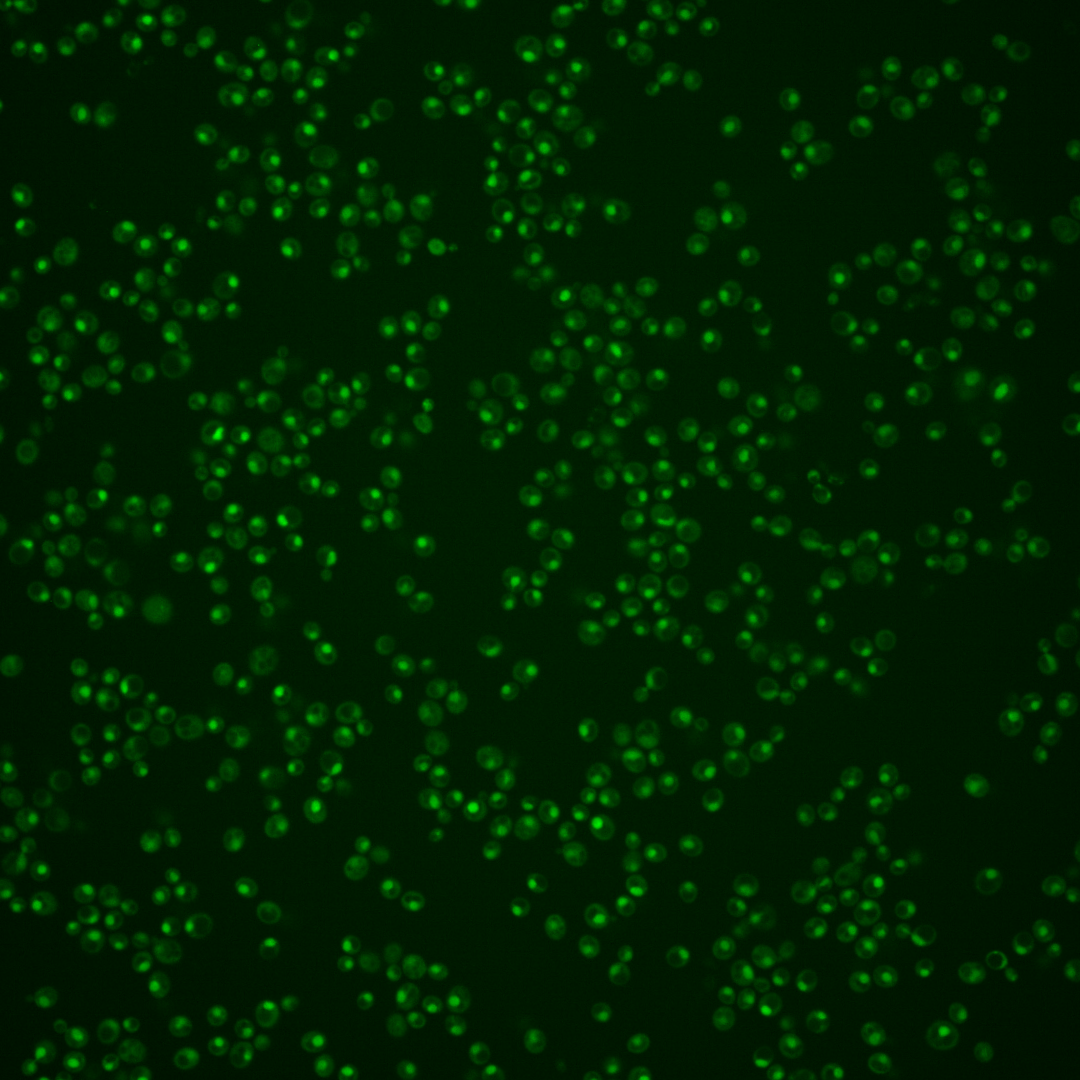
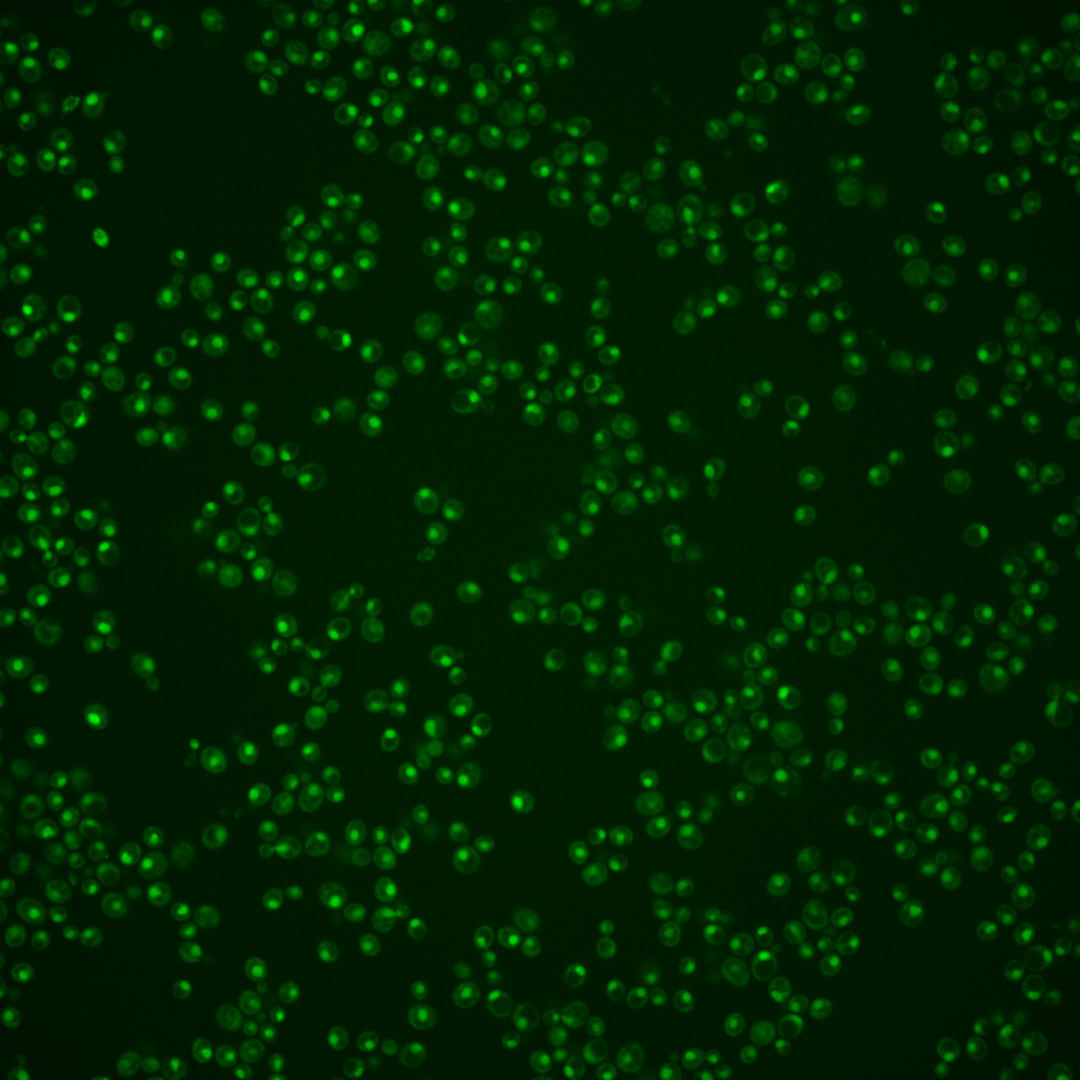

| Standard name | |
|---|---|
| Human Ortholog | |
| Description | Putative tRNA acetyltransferase; RNA-binding protein required for the formation of the modified nucleoside N(4)-acetylcytidine in serine and leucine tRNAs but not required for the same modification in 18S rRNA; protein abundance increases in response to DNA replication stress |
Micrographs




















































































Sub-cellular Localization
Yeast GFP Assignment
Protein Abundance
Localization Change
External localization resources
| ensLOC | DeepLoc | |||||||||||||||||||||||
|---|---|---|---|---|---|---|---|---|---|---|---|---|---|---|---|---|---|---|---|---|---|---|---|---|
| Localization | WT1 | WT2 | WT3 | RAP60 | RAP140 | RAP220 | RAP300 | RAP380 | RAP460 | RAP540 | RAP620 | RAP700 | HU80 | HU120 | HU160 | rpd3Δ_1 | rpd3Δ_2 | rpd3Δ_3 | WT1 | WT2 | WT3 | AF100 | AF140 | AF180 |
| Cortical Patches | 0 | 0 | 0 | 0 | 0 | 0 | 0 | 0 | 0 | 0 | 0 | 0 | 0 | 0 | 0 | 0 | 0 | 0 | 0 | 2 | 1 | 0 | 0 | 0 |
| Bud | 0 | 0 | 0 | 0 | 5 | 0 | 0 | 6 | 9 | 9 | 6 | 0 | 0 | 0 | 2 | 0 | 0 | 1 | 4 | 6 | 3 | 3 | 0 | 3 |
| Bud Neck | 0 | 0 | 1 | 0 | 1 | 0 | 0 | 0 | 2 | 1 | 1 | 0 | 1 | 0 | 0 | 0 | 0 | 0 | 0 | 0 | 0 | 0 | 1 | 3 |
| Bud Site | 1 | 0 | 0 | 2 | 1 | 6 | 3 | 4 | 22 | 20 | 23 | 25 | 0 | 0 | 0 | 0 | 2 | 0 | – | – | – | – | – | – |
| Cell Periphery | 0 | 0 | 1 | 0 | 0 | 0 | 0 | 0 | 0 | 0 | 0 | 0 | 1 | 0 | 0 | 0 | 0 | 0 | 0 | 0 | 0 | 0 | 0 | 0 |
| Cytoplasm | 5 | 25 | 19 | 20 | 27 | 25 | 34 | 56 | 41 | 19 | 16 | 12 | 51 | 71 | 71 | 28 | 27 | 28 | 3 | 4 | 1 | 6 | 6 | 5 |
| Endoplasmic Reticulum | 1 | 2 | 0 | 0 | 0 | 0 | 0 | 1 | 0 | 0 | 0 | 0 | 0 | 0 | 1 | 5 | 8 | 9 | 0 | 0 | 1 | 1 | 2 | 0 |
| Endosome | 1 | 0 | 0 | 0 | 0 | 5 | 4 | 6 | 0 | 2 | 1 | 0 | 3 | 0 | 1 | 0 | 3 | 1 | 1 | 5 | 4 | 7 | 6 | 9 |
| Golgi | 0 | 0 | 0 | 1 | 0 | 1 | 0 | 0 | 0 | 0 | 0 | 0 | 0 | 0 | 0 | 0 | 0 | 1 | 1 | 7 | 0 | 2 | 1 | 0 |
| Mitochondria | 12 | 28 | 1 | 38 | 71 | 62 | 86 | 73 | 385 | 161 | 206 | 199 | 0 | 1 | 1 | 18 | 8 | 3 | 0 | 6 | 4 | 7 | 11 | 12 |
| Nucleus | 271 | 588 | 430 | 427 | 380 | 587 | 630 | 616 | 495 | 591 | 444 | 489 | 446 | 442 | 429 | 319 | 311 | 224 | 256 | 575 | 402 | 285 | 215 | 247 |
| Nuclear Periphery | 0 | 5 | 0 | 0 | 0 | 6 | 10 | 7 | 9 | 17 | 6 | 4 | 2 | 5 | 1 | 12 | 10 | 8 | 0 | 0 | 1 | 3 | 4 | 13 |
| Nucleolus | 7 | 6 | 1 | 2 | 4 | 2 | 7 | 19 | 31 | 25 | 28 | 13 | 1 | 4 | 5 | 8 | 6 | 5 | 13 | 18 | 16 | 29 | 29 | 52 |
| Peroxisomes | 0 | 0 | 0 | 0 | 0 | 0 | 0 | 0 | 0 | 0 | 0 | 0 | 0 | 0 | 1 | 0 | 0 | 0 | 0 | 0 | 1 | 0 | 0 | 0 |
| SpindlePole | 0 | 1 | 4 | 2 | 4 | 3 | 3 | 10 | 6 | 5 | 5 | 2 | 1 | 3 | 6 | 2 | 3 | 3 | 3 | 2 | 4 | 5 | 6 | 8 |
| Vac/Vac Membrane | 6 | 16 | 5 | 7 | 8 | 18 | 16 | 29 | 12 | 16 | 9 | 12 | 5 | 4 | 7 | 7 | 18 | 11 | 12 | 34 | 28 | 55 | 66 | 93 |
| Unique Cell Count | 286 | 642 | 457 | 460 | 436 | 658 | 728 | 748 | 688 | 709 | 555 | 594 | 504 | 519 | 517 | 358 | 365 | 266 | 300 | 671 | 476 | 413 | 358 | 458 |
| Labelled Cell Count | 304 | 671 | 462 | 499 | 501 | 715 | 793 | 827 | 1012 | 866 | 745 | 756 | 511 | 530 | 525 | 399 | 396 | 294 | 300 | 671 | 476 | 413 | 358 | 458 |
Yeast GFP Assignment
Protein Abundance
| Screen | WT1 | WT2 | WT3 | RAP60 | RAP140 | RAP220 | RAP300 | RAP380 | RAP460 | RAP540 | RAP620 | RAP700 | HU80 | HU120 | HU160 | rpd3Δ_1 | rpd3Δ_2 | rpd3Δ_3 | AF100 | AF140 | AF180 |
|---|---|---|---|---|---|---|---|---|---|---|---|---|---|---|---|---|---|---|---|---|---|
| Mean Cell GFP Intensity (1e-4) | 6.1 | 5.7 | 6.7 | 5.8 | 5.2 | 5.4 | 5.3 | 5.6 | 4.2 | 5.0 | 4.6 | 4.8 | 6.7 | 6.5 | 6.2 | 6.7 | 8.1 | 8.2 | 6.9 | 7.4 | 7.2 |
| Std Deviation (1e-4) | 1.2 | 1.0 | 1.3 | 1.2 | 1.4 | 1.3 | 1.2 | 1.4 | 1.1 | 0.9 | 1.0 | 0.8 | 1.5 | 1.3 | 1.3 | 1.4 | 2.0 | 2.3 | 1.5 | 1.5 | 1.5 |
| Intensity Change (Log2) | – | – | – | -0.21 | -0.35 | -0.3 | -0.33 | -0.25 | -0.66 | -0.43 | -0.54 | -0.49 | 0.0 | -0.04 | -0.1 | -0.0 | 0.28 | 0.29 | 0.06 | 0.14 | 0.11 |
Localization Change
| Localization | RAP60 | RAP140 | RAP220 | RAP300 | RAP380 | RAP460 | RAP540 | RAP620 | RAP700 | HU80 | HU120 | HU160 | rpd3Δ_1 | rpd3Δ_2 | rpd3Δ_3 |
|---|---|---|---|---|---|---|---|---|---|---|---|---|---|---|---|
| Cortical Patches | 0 | 0 | 0 | 0 | 0 | 0 | 0 | 0 | 0 | 0 | 0 | 0 | 0 | 0 | 0 |
| Bud | 0 | 0 | 0 | 0 | 0 | 0 | 0 | 0 | 0 | 0 | 0 | 0 | 0 | 0 | 0 |
| Bud Neck | 0 | 0 | 0 | 0 | 0 | 0 | 0 | 0 | 0 | 0 | 0 | 0 | 0 | 0 | 0 |
| Bud Site | 0 | 0 | 0 | 0 | 0 | 0 | 3.6 | 0 | 0 | 0 | 0 | 0 | 0 | 0 | 0 |
| Cell Periphery | 0 | 0 | 0 | 0 | 0 | 0 | 0 | 0 | 0 | 0 | 0 | 0 | 0 | 0 | 0 |
| Cytoplasm | 0.1 | 1.4 | -0.3 | 0.4 | 2.3 | 1.3 | -1.4 | -1.1 | -2.0 | 3.6 | 5.1 | 5.1 | 2.2 | 2.0 | 3.3 |
| Endoplasmic Reticulum | 0 | 0 | 0 | 0 | 0 | 0 | 0 | 0 | 0 | 0 | 0 | 0 | 0 | 0 | 0 |
| Endosome | 0 | 0 | 0 | 0 | 0 | 0 | 0 | 0 | 0 | 0 | 0 | 0 | 0 | 0 | 0 |
| Golgi | 0 | 0 | 0 | 0 | 0 | 0 | 0 | 0 | 0 | 0 | 0 | 0 | 0 | 0 | 0 |
| Mitochondria | 6.0 | 8.8 | 6.5 | 7.4 | 6.7 | 0 | 10.8 | 0 | 0 | 0 | 0 | 0 | 4.5 | 0 | 0 |
| Nucleus | -0.8 | -3.6 | -2.8 | -4.1 | -5.8 | -9.3 | -5.4 | -6.5 | -5.7 | -3.1 | -4.5 | -5.4 | -2.6 | -4.2 | -4.4 |
| Nuclear Periphery | 0 | 0 | 0 | 0 | 0 | 0 | 3.3 | 0 | 0 | 0 | 0 | 0 | 3.9 | 0 | 0 |
| Nucleolus | 0 | 0 | 0 | 0 | 3.1 | 0 | 3.7 | 0 | 0 | 0 | 0 | 0 | 0 | 0 | 0 |
| Peroxisomes | 0 | 0 | 0 | 0 | 0 | 0 | 0 | 0 | 0 | 0 | 0 | 0 | 0 | 0 | 0 |
| SpindlePole | 0 | 0 | 0 | 0 | 0.7 | 0 | 0 | 0 | 0 | 0 | 0 | 0 | 0 | 0 | 0 |
| Vacuole | 0.6 | 0.9 | 1.9 | 1.4 | 2.8 | 0.9 | 1.5 | 0.7 | 1.2 | 0 | 0 | 0.4 | 1.0 | 3.3 | 2.7 |
External localization resources
Images






























Protein Concentration and Protein Localization Data
| R1 | R2 | R3 | ||||||||||||||||
|---|---|---|---|---|---|---|---|---|---|---|---|---|---|---|---|---|---|---|
| G1 Pre-START | G1 Post-START | S/G2 | Metaphase | Anaphase | Telophase | G1 Pre-START | G1 Post-START | S/G2 | Metaphase | Anaphase | Telophase | G1 Pre-START | G1 Post-START | S/G2 | Metaphase | Anaphase | Telophase | |
| Concentration | 3.6596 | 4.2869 | 3.764 | 3.5856 | 3.1801 | 3.7068 | 7.5824 | 6.9073 | 7.486 | 7.6629 | 7.044 | 7.3078 | 4.5848 | 4.4793 | 4.0759 | 4.6715 | 3.7827 | 4.4499 |
| Actin | 0.0246 | 0 | 0.0004 | 0.0026 | 0.0433 | 0.0004 | 0.0165 | 0.0004 | 0.0015 | 0.0001 | 0.0002 | 0.0035 | 0.0003 | 0 | 0 | 0 | 0 | 0 |
| Bud | 0.0003 | 0.0001 | 0 | 0.0004 | 0.0005 | 0.0001 | 0.0002 | 0.0008 | 0.0001 | 0.0001 | 0.0001 | 0.0001 | 0 | 0 | 0 | 0 | 0 | 0 |
| Bud Neck | 0.0058 | 0.0002 | 0.0006 | 0.0012 | 0.0009 | 0.0014 | 0.0006 | 0.0009 | 0.0058 | 0.0007 | 0.0011 | 0.0012 | 0.0004 | 0.0001 | 0.0001 | 0.0003 | 0.0002 | 0.0009 |
| Bud Periphery | 0.0007 | 0.0001 | 0.0001 | 0.0009 | 0.0007 | 0.0001 | 0.0004 | 0.0014 | 0.0002 | 0.0005 | 0.0001 | 0.0005 | 0.0001 | 0 | 0 | 0.0001 | 0.0001 | 0.0001 |
| Bud Site | 0.0049 | 0.0002 | 0.0002 | 0.0049 | 0.0019 | 0.0002 | 0.0008 | 0.0035 | 0.0035 | 0.0004 | 0.0006 | 0.0001 | 0.0001 | 0.0001 | 0.0001 | 0.0001 | 0.0001 | 0.0001 |
| Cell Periphery | 0.0004 | 0 | 0.0001 | 0.0004 | 0.0001 | 0.0001 | 0.0001 | 0.0004 | 0.0002 | 0.0001 | 0.0001 | 0.0001 | 0 | 0 | 0 | 0.0001 | 0 | 0 |
| Cytoplasm | 0.0016 | 0.0001 | 0.0003 | 0.0026 | 0.0004 | 0.0001 | 0.0063 | 0.0046 | 0.0003 | 0.0001 | 0.0007 | 0.0003 | 0.0008 | 0.0001 | 0 | 0.0001 | 0 | 0 |
| Cytoplasmic Foci | 0.0157 | 0 | 0.0023 | 0.0309 | 0.0026 | 0.0014 | 0.0068 | 0.0003 | 0.0068 | 0 | 0.015 | 0.0001 | 0.0001 | 0 | 0 | 0 | 0 | 0 |
| Eisosomes | 0.0004 | 0 | 0.0002 | 0.0001 | 0.0002 | 0 | 0.0002 | 0 | 0 | 0 | 0.0003 | 0 | 0 | 0 | 0 | 0 | 0 | 0 |
| Endoplasmic Reticulum | 0.0006 | 0 | 0.0007 | 0.0049 | 0.0044 | 0 | 0.0019 | 0.0001 | 0.0001 | 0.0001 | 0.0002 | 0.0013 | 0.0006 | 0 | 0 | 0 | 0 | 0 |
| Endosome | 0.0088 | 0 | 0.0026 | 0.0388 | 0.0209 | 0.0008 | 0.0165 | 0.0007 | 0.0032 | 0.0001 | 0.0009 | 0.0005 | 0.0008 | 0 | 0 | 0 | 0 | 0 |
| Golgi | 0.0057 | 0 | 0.0006 | 0.0076 | 0.0124 | 0.0006 | 0.0073 | 0.0002 | 0.0021 | 0 | 0.0002 | 0.0001 | 0.0001 | 0 | 0 | 0 | 0 | 0 |
| Lipid Particles | 0.014 | 0 | 0.0068 | 0.0739 | 0.0023 | 0.0125 | 0.0209 | 0.0002 | 0.0074 | 0 | 0.0014 | 0.0001 | 0.0002 | 0 | 0 | 0 | 0 | 0 |
| Mitochondria | 0.0103 | 0.0003 | 0.0017 | 0.0032 | 0.005 | 0.0087 | 0.0091 | 0.0054 | 0.0039 | 0.001 | 0.0012 | 0.0002 | 0.0003 | 0.0001 | 0.0001 | 0.0001 | 0.0002 | 0.0001 |
| None | 0.0039 | 0 | 0.0024 | 0.0016 | 0.0005 | 0.0001 | 0.0027 | 0.0002 | 0.0004 | 0.0001 | 0.0325 | 0.0002 | 0.0002 | 0 | 0 | 0 | 0 | 0 |
| Nuclear Periphery | 0.0019 | 0.001 | 0.003 | 0.0398 | 0.0108 | 0.0004 | 0.0105 | 0.0104 | 0.001 | 0.0491 | 0.0054 | 0.0033 | 0.0146 | 0.0007 | 0.0005 | 0.0025 | 0.0004 | 0.0003 |
| Nucleolus | 0.0527 | 0.0614 | 0.0779 | 0.1272 | 0.0795 | 0.1039 | 0.0389 | 0.1011 | 0.0351 | 0.0593 | 0.1086 | 0.0871 | 0.0254 | 0.0469 | 0.0453 | 0.1041 | 0.1139 | 0.1011 |
| Nucleus | 0.8127 | 0.9358 | 0.8951 | 0.625 | 0.8072 | 0.858 | 0.8331 | 0.8611 | 0.9173 | 0.8868 | 0.7988 | 0.895 | 0.9515 | 0.9502 | 0.9531 | 0.8899 | 0.8844 | 0.896 |
| Peroxisomes | 0.0176 | 0 | 0.0018 | 0.0132 | 0.0017 | 0.01 | 0.003 | 0.0005 | 0.0083 | 0 | 0.0005 | 0 | 0 | 0 | 0 | 0 | 0 | 0 |
| Punctate Nuclear | 0.015 | 0.0005 | 0.0015 | 0.0127 | 0.0015 | 0.0008 | 0.0202 | 0.001 | 0.0019 | 0.0005 | 0.0319 | 0.0057 | 0.0037 | 0.0016 | 0.0005 | 0.002 | 0.0006 | 0.001 |
| Vacuole | 0.0018 | 0.0002 | 0.001 | 0.006 | 0.0009 | 0.0003 | 0.0021 | 0.0056 | 0.0008 | 0.0006 | 0.0003 | 0.0005 | 0.0003 | 0.0001 | 0.0001 | 0.0005 | 0.0001 | 0.0002 |
| Vacuole Periphery | 0.0006 | 0.0001 | 0.0007 | 0.0021 | 0.0021 | 0.0002 | 0.0018 | 0.0012 | 0.0002 | 0.0004 | 0.0001 | 0.0002 | 0.0003 | 0 | 0 | 0.0001 | 0.0001 | 0 |
Sequencing Data
| R1 | R2 | |||||||||
|---|---|---|---|---|---|---|---|---|---|---|
| G1 Post-START | S/G2 | Metaphase | Anaphase | Telophase | G1 Post-START | S/G2 | Metaphase | Anaphase | Telophase | |
| Gene Expression | 41.2191 | 45.3506 | 46.2717 | 46.1473 | 47.6871 | 27.8867 | 49.5796 | 42.9408 | 42.2044 | 47.9414 |
| Translational Efficiency | 1.4763 | 1.463 | 1.4013 | 1.548 | 1.4002 | 2.4211 | 1.3207 | 1.5587 | 1.4933 | 1.52 |
Hit Data
| Dataset | Hit |
|---|---|
| Protein Concentration | ✘ |
| Protein Localization | ✘ |
| Gene Expression | ✘ |
| Translational Efficiency | ✘ |
Endocytosis
| Temp | Actin Patch (Sac6-tdTomato) | Cortical Patch (Sla1-GFP) | Late Endosome (Snf7-GFP) | Vacuole (Vph1-GFP) |
|---|---|---|---|---|
| 37℃ | ||||
| RT |
Cell Cycle Omics
CYCLoPs (Tan1-GFP)
| Gene / Allele | Actin Patch (Sac6-tdTomato) | Cortical Patch (Sla1-GFP) | Late Endosome (Snf7-GFP) | Vacuole (Sac6-tdTomato) |
|---|
| Gene | Images |
|---|
| Gene | Images |
|---|
Images are not yet available
Images are not yet available